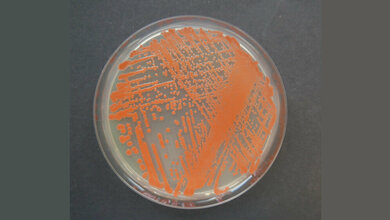
Reinkultur der Roten Hefe Rhodotorula mucilaginosa

Als kleine „Zellfabriken“ stellen sie Medikamente und Rohstoffe in industriellem Maßstab her. Diesen für unseren Genuss und nachhaltige Produktion bedeutenden Mikroorganismus wählte die Vereinigung für Allgemeine und Angewandte Mikrobiologie (VAAM) zur Mikrobe des Jahres 2022. „Zuckerpilz des Bieres“ bedeutet der lateinische Name Saccharomyces cerevisiae. Die Mikrobe des Jahres 2022 ist ein großer Braumeister, obwohl sie so winzig ist, dass zehn ihrer Zellen gestapelt gerade mal die Dicke von Papier erreichen. Sichtbar wurde die Brauhefe erst mit der Erfindung des Lichtmikroskops (1680) in Form vieler kleiner Teilchen, die das Bier trübe machen. Es dauerte fast 200 weitere Jahre, bis Louis Pasteur lebende Hefezellen als Ursache für die alkoholische Gärung erkannte.
Hefefermentation seit Jahrtausenden genutzt
Natürlicherweise ernähren sich Hefezellen von Zuckerverbindungen aus Blättern und Früchten. Sie bauen Glukose oder Fruktose zu Kohlendioxid-Bläschen (CO₂) und dem Alkohol Ethanol ab. Der Alkohol verschafft der Hefe einen Vorteil: Er tötet konkurrierende Mikroorganismen. Hat die Hefe den Zucker vernascht, kann sie den selbst produzierten Ethanol weiter abbauen. Die Hefefermentation nutzen die Menschen seit Jahrtausenden: Schon die alten Ägypter stellten eine Art Bier her. In früheren Jahrhunderten war dies ein Getränk selbst für Kinder, weil es viel keimärmer war als das häufig verschmutzte Wasser. Auch Wein und Sake beruhen auf der Gärtätigkeit von Hefe. Zur Schaumbildung beim Sekt wird in der zweiten Gärung eine Hefevariante (Saccharomyces bayanus) eingesetzt, die auf drei verschiedene Hefen zurückgeht, darunter die Bäckerhefe.
Verwendung als Backtriebmittel
Die einzelligen Hefepilze produzieren auch im Kuchenteig Kohlendioxid-Bläschen: Mehl besteht aus verknüpften Zuckern (Kohlenhydraten), die Saccharoymces cerevisiae zu CO₂ umsetzt. Durch kräftiges Kneten verteilen sich die Hefezellen im Teig; leichte Wärme regt ihren Stoffwechsel und ihre Vermehrung an. Die entstehenden Bläschen lassen den Hefeteig locker werden – er geht auf. Bäckereien, Brauereien, Wein- und Sektkellereien verwenden eine Vielzahl unterschiedlicher Hefestämme und -arten. Im für Brot verwendeten Sauerteig unterstützen Milchsäurebakterien die Hefe. Die genaue Zusammensetzung und ihre Einsatzbedingungen sind häufig gut gehütete Betriebsgeheimnisse.
Verwendung als biotechnologischer Modellorganismus
Saccharomyces cerevisiae war der erste eukaryotische Organismus mit vollständig sequenziertem Genom. Heute gibt es Stammsammlungen, in denen jedes einzelne der ca. 6.300 Hefegene veränderbar ist. Am Modellorganismus Bäckerhefe lässt sich vergleichsweise einfach der grundlegende Aufbau und die Funktion eukaryotischer Zellen untersuchen, denn Hefezellen sind ähnlich aufgebaut wie menschliche Zellen. Hefezellen dienen auch als zelluläre Fabrik. Davon profitieren beispielsweise Diabetiker seit Jahrzehnten: In das Hefegenom wurde das menschliche Insulin-Gen „eingepflanzt“, sodass dieser winzige Organismus einen Großteil des menschlichen Hormons für die Diabetestherapie produziert. Forscherteams versetzten die Hefe zudem mit Hilfe von Genen aus Pilzen und Bakterien in die Lage, natürliche Zucker aus Holz (Xylose) in Ethanol umzuwandeln. Damit können pflanzliche Abfallstoffe heute als Rohstoff und Energiequelle dienen. Veränderte Hefezellen können auch Bernsteinsäure herstellen, einen Baustein zur industriellen Herstellung von Polyester. Der Malaria-Wirkstoff Artemisinin (2015 mit dem Nobelpreis ausgezeichnet) wird durch eine ausgefeilte „Umleitung“ des Hefe-Stoffwechsel produziert. Dieser Prozess diente auch als Ausgangsbasis für die Herstellung des chemisch verwandten Ersatz-Flugzeugkraftstoffs Farnesen.
Sie besitzen membranumschlossene Organellen
Für die Biotechnologie spielt eine Eigenschaft eine wichtige Rolle, die Hefen wie alle Eukaryoten auszeichnet: Sie besitzen membranumschlossene Organellen, die eine räumliche Trennung verschiedener biochemischer Prozesse erlauben. Damit lassen sich beispielsweise giftige Zwischenstufen innerhalb der Zelle abtrennen. So ist es Forschern kürzlich gelungen, Enzyme für die Vorstufe von Nylon in bläschenartige Vesikel zu „verpacken“. Das zeigt beispielhaft, wie die Arbeitsteilung in der Zelle durch neue Reaktionsräume optimiert werden kann. Die Wissenschaftler sind überzeugt davon, dass Saccharomyces cerevisiae bei der gesellschaftlichen Transformation zu nachhaltigeren Wirtschaftsformen eine wichtige Rolle spielen werde.
Über die Mikrobe des Jahres
Die Mikrobe des Jahres weist auf die bedeutsame Rolle der Mikroorganismen für die Ökologie, Gesundheit, Ernährung und Wirtschaft hin. Mikrobiolog:innen der Vereinigung für Allgemeine und Angewandte Mikrobiologie (VAAM) wählen sie jedes Jahr aus, um auf die Vielfalt der mikrobiologischen Welt aufmerksam zu machen.
Quelle: idw/Verband Biologie, Biowissenschaften und Biomedizin in Deutschland e.V.
Artikel teilen